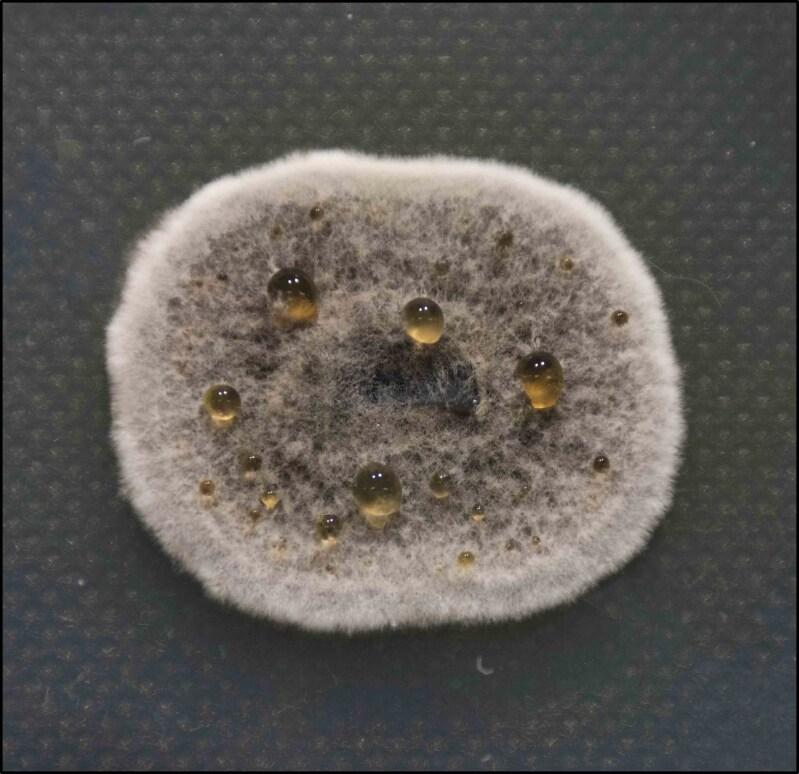
https://cdn.ncbi.nlm.nih.gov/pmc/blobs/d891/11908538/ca61bda074b2/dkaf005f4.jpg

非曲霉菌属霉菌引起的侵袭性真菌感染的诊断与管理
Diagnosis and management of invasive fungal infections due to non-Aspergillus moulds.
作者信息
Morrissey C Orla
机构信息
Department of Infectious Diseases, Alfred Health, Melbourne, Victoria, Australia.
Department of Infectious Diseases, School of Translational Medicine, Monash University, Melbourne, Victoria, Australia.
出版信息
J Antimicrob Chemother. 2025 Mar 14;80(Supplement_1):i17-i39. doi: 10.1093/jac/dkaf005.
Invasive fungal infection (IFI) due to moulds other than Aspergillus are a significant cause of morbidity and mortality. Non-Aspergillus mould (NAM) infections appear to be on the increase due to an ever-expanding population of immunocompromised hosts. In this review, Mucorales, Scedosporium species, Lomentospora prolificans and Fusarium species are examined in detail, and the microbiology, risk factors, diagnosis and treatment of emerging NAMs such as Paecilomyces variotti, Purpureocillium lilacinum and Rasamsonia are summarized. The challenges in diagnosis are emphasized and the emerging importance of molecular methods is discussed. Treatment of IFI due to NAMs is a multi-pronged and multi-disciplinary approach. Surgery, correction of underlying risk factors, and augmentation of the host immune response are as important as antifungal therapy. Many of these NAMs are intrinsically resistant to the currently licensed antifungal agents, so selection of therapy needs to be guided by susceptibility testing. There are new antifungal agents in development, and these have the potential to improve the efficacy and safety of antifungal treatment in the future. Ongoing research is required to fully delineate the epidemiology of NAM infections, and to develop better diagnostic tools and treatments so that outcomes from these infections can continue to improve.
由曲霉菌以外的霉菌引起的侵袭性真菌感染(IFI)是发病和死亡的重要原因。由于免疫功能低下宿主群体不断扩大,非曲霉菌霉菌(NAM)感染似乎呈上升趋势。在本综述中,对毛霉目、帚霉属、多育镰刀菌和镰刀菌属进行了详细研究,并总结了诸如拟青霉、淡紫紫孢菌和拉氏菌等新兴NAM的微生物学、危险因素、诊断和治疗方法。强调了诊断方面的挑战,并讨论了分子方法日益重要的作用。治疗由NAM引起的IFI需要采取多方面、多学科的方法。手术、纠正潜在危险因素以及增强宿主免疫反应与抗真菌治疗同样重要。这些NAM中的许多对目前已获许可的抗真菌药物具有内在抗性,因此治疗选择需要以药敏试验为指导。目前正在研发新的抗真菌药物,这些药物有可能在未来提高抗真菌治疗的疗效和安全性。需要持续开展研究,以全面描述NAM感染的流行病学情况,并开发更好的诊断工具和治疗方法,从而使这些感染的治疗效果不断改善。